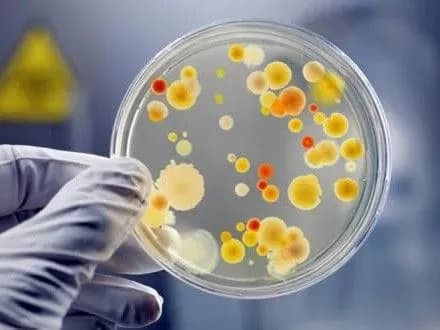
Працівникам інтернату винесли догани за спалах гепатиту А серед дітей на Житомирщині

Працівникам інтернату винесли догани за спалах гепатиту А серед дітей на Житомирщині
Київ • УНН
КИЇВ. 25 листопада. УНН. Чотирьом працівникам Кмитівської школи-інтернату, з вини яких діти захворіли на гепатит А, оголошено догани на Житомирщині. Про це УНН повідомили у прес-службі прокуратури Житомирської області.
Так, у Кмитівській школі-інтернаті стався спалах гепатиту А сере дітей, їх госпіталізували до інфекційного відділення дитячої обласної лікарні. Усього на стаціонарному лікуванні із середнім і легким ступенем тяжкості перебігу хвороби перебувало 34 вихованця школи-інтернату.
За результатами службової перевірки, до дисциплінарної відповідальності притягнуто чотирьох працівників Кмитівської школи-інтернату, з вини яких стався спалах вірусного гепатиту А. Зокрема, оголошено догани заступнику директора з господарської роботи навчального закладу та трьом іншим працівникам з обслуговуючого персоналу.
Дотепер на стаціонарному лікуванні медичних закладів перебуває 16 учнів віком від 6 до 15 років.
Досудове розслідування триває.
